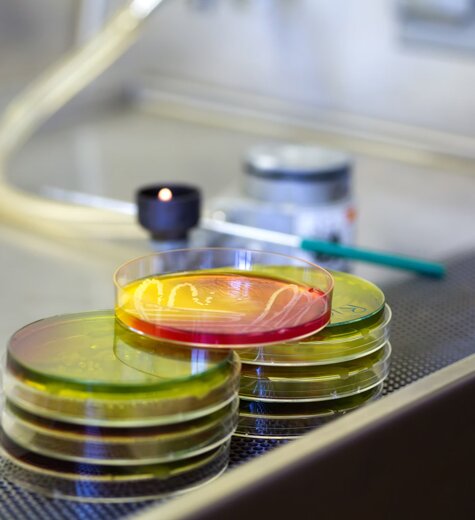
imgi_5_69373c_c7b3cfe344604c56afa942c146ec3559~mv2.jpeg

certificazioni
UNI EN ISO 9001:2015
H.A.C.C.P.
Quali attività hanno l’obbligo di mettersi in regola con la normativa HACCP? Cosa sono i corsi di formazione HACCP? Queste e altre domande sono basilari per molteplici attività commerciali e produttive e meritano adeguate risposte.
Forniamo ai nostri clienti un servizio di consulenza immediato e completo in materia di HACCP, igiene alimentare e sicurezza sul posto di lavoro.
In particolare: